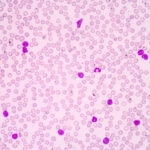

In the realm of pediatric medicine, the dimensions of critical care undergo continuous scrutiny and innovation. A recent study reveals significant advancements in assessing children undergoing treatment in intensive care units. The investigation, led by Salehpoor-Emran, Panjo, and Nazari, is set to make waves in the medical community as it critically examines the efficacy of the Pediatric Critical Care Observation Tool (P-CPOT). This valuable tool emerges as a beacon of hope for medical practitioners aiming to enhance diagnostic accuracy and ultimately improve patient outcomes among our most vulnerable population: children.
The study highlights the necessity of reliable observation tools in pediatric critical care settings, where traditional assessments can often prove insufficient. Children, particularly those facing life-threatening conditions, are often unable to communicate their needs or discomfort effectively. Thus, the implementation of an observational tool like P-CPOT is not merely beneficial; it is vital. By examining physiological parameters and behavioral cues, this tool forms a comprehensive framework that paves the way for timely interventions, crucial in a fast-paced ICU environment.
The P-CPOT, designed with the intent to bridge gaps in pediatric care, allows healthcare professionals to analyze a child’s pain levels with greater accuracy. By synthesizing both observational and clinical data, the tool guides caregivers in recognizing subtle changes in a child’s condition that may not be readily apparent. This, in turn, can significantly affect how quickly and effectively a child receives necessary treatments, thus ensuring that care is both proactive and tailored to individual needs.
During the study conducted in 2021, researchers rigorously applied the P-CPOT among children admitted to a pediatric intensive care unit (PICU). The comparative methodology employed by the researchers aimed to contrast the P-CPOT’s observational findings with standard assessment tactics previously utilized in such settings. This approach allows for a clearer perspective on how the P-CPOT performs against established norms, offering insights that are both informative and critically valuable for clinical best practices.
The significance of this investigation lies not only in its immediate findings but also in its broader implications for pediatric healthcare. As the research unravels, it beckons healthcare providers to rethink their approaches to pain management, especially in contexts where verbal communication is limited. The pressing question of how best to assess pain in children, often described as “the silent burden,” receives much-needed attention through this groundbreaking study, promoting ongoing dialogue among practitioners.
Moreover, the findings are expected to resonate beyond the boundaries of the specific PICU where the study was conducted. Hospitals across the world are continually searching for methodologies that improve the care they provide to their young patients. By adopting tools like the P-CPOT, healthcare systems may be able to standardize pain assessments in pediatric units globally, hence improving practices around the world. The ripple effect of this research could lead to more uniformly excellent care for children in critical conditions.
A careful examination of the data collected during the comparative study will also introduce pivotal insights into the relationship between pain measurement and recovery timelines. Understanding how a more accurate assessment of pain correlates with post-intensive care recovery rates could usher in innovative protocols tailored around patient experiences, leading to not just better clinical outcomes, but also heightened parental satisfaction and confidence in the care their children receive.
In totality, the outcomes of this research elevate the discussion around pediatric pain assessment and management. The team of researchers behind this study not only seeks to validate the P-CPOT but also encourages healthcare professionals to embrace a mindset of continuous improvement and adaptation in critical care practices. As innovations in medicine evolve, the capacity for clinical adaptation becomes paramount, urging practitioners to remain vigilant in seeking better solutions for patients.
As the medical community processes these findings, the hope is that such a tool will not only assist in acute care settings but also influence chronic care approaches for pediatric patients. Developing a deeper understanding of a child’s baseline behavior and physiological signals can effectively demystify pain management over time, enabling families and healthcare providers to collaboratively manage care after an initial ICU stay.
The implications of this study are vast, targeting not only the clinical aspects of pediatric care but also extending to training and educational realms. By integrating P-CPOT into training programs for nurses and physicians, new generations of clinicians may be better equipped to navigate the complexities of pain assessment in children. This focus on education will invariably shape a more compassionate and informed healthcare workforce, committed to providing the best possible outcomes for their young patients.
Conclusively, the ongoing research into the P-CPOT symbolizes a progressive stride in pediatric healthcare. As the results are disseminated across platforms, the hope is that pediatric units around the globe will adopt such evidence-based tools that can transform the landscape of critical care medicine, enhancing not just patient safety but also the quality of life for children burdened by illness.
The study by Salehpoor-Emran, Panjo, and Nazari doesn’t just remain an academic exercise; rather, it becomes a powerful call to action for stakeholders within pediatric healthcare. Scientifically backed assessments like the P-CPOT are poised to revolutionize how healthcare professionals observe and intervene in the care of critically ill children, leading to a future where every child can receive the empathy and precision they deserve in their healthcare journey.
In an age where the importance of scientific inquiry and its translation into practice cannot be overstated, this study is an essential contribution to the evolving narrative of pediatric care. It emphasizes the critical need for continued research, discussion, and action in pursuit of nurturing the health and wellbeing of children everywhere, reminding us all of the profound impact such endeavors can have.
Subject of Research: Pediatric critical care observation tool (P-CPOT) and its diagnostic value among children in PICU.
Article Title: Investigating the diagnostic value of the pediatric critical care observation tool (P-CPOT) among children hospitalized in the pediatric intensive care unit in 2021- a comparative study.
Article References:
Salehpoor-Emran, M., Panjo, M. & Nazari, R. Investigating the diagnostic value of the pediatric critical care observation tool (P-CPOT) among children hospitalized in the pediatric intensive care unit in 2021- a comparative study. BMC Pediatr 25, 817 (2025). https://doi.org/10.1186/s12887-025-06231-1
Image Credits: AI Generated
DOI: 10.1186/s12887-025-06231-1
Keywords: Pediatric care, critical care, observation tool, P-CPOT, pain management, pediatric intensive care unit, comparative study, diagnostics, healthcare innovation.
Tags: Behavioral cues in pediatric medicineCritical care innovations in pediatricsEnhancing diagnostic accuracy in childrenImproving pediatric patient outcomesLife-threatening conditions in pediatricsObservational tools in healthcareP-CPOT effectiveness studyPediatric critical care observationPediatric ICU diagnostic toolsPediatric intensive care advancementsPediatric pain assessment methodsPhysiological assessment in critical care